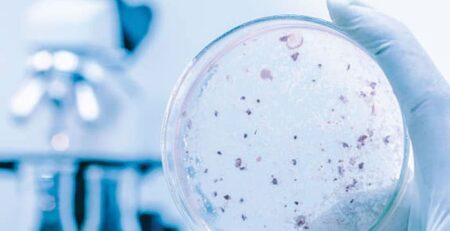

Légionellose : ses méfaits dans les canalisations et les solutions pour la traiter
La légionellose est une maladie respiratoire grave provoquée par la bactérie Legionella pneumophila. Elle peut être présente dans divers environnements, mais l’un de ses habitats préférés est celui des systèmes de canalisations d’eau chaude. Notamment les réseaux de distribution d’eau potable, les tours de refroidissement, les spas et les bains à remous.
Cette bactérie se multiplie rapidement dans des conditions propices. Elle peut d’ailleurs entraîner des risques pour la santé humaine lorsque les gouttelettes d’eau contaminée sont inhalées.
Les méfaits de la légionellose dans les canalisations sont multiples :
- Risque pour la santé humaine : L’inhalation de gouttelettes d’eau contenant la bactérie Legionella pneumophila peut provoquer une pneumonie sévère, connue sous le nom de pneumonie légionellosique, chez les individus sensibles. Les personnes âgées, les fumeurs, les personnes souffrant de maladies respiratoires chroniques et les individus dont le système immunitaire est affaibli sont particulièrement vulnérables.
- Dommages matériels : La présence de Legionella dans les canalisations peut également causer des problèmes matériels. Les biofilms bactériens qui se forment à l’intérieur des canalisations peuvent obstruer les tuyaux et les équipements de plomberie, entraînant des réparations coûteuses.
- Impacts économiques : Les épidémies de légionellose peuvent avoir des conséquences économiques importantes. Elles entraînent notamment des coûts médicaux élevés pour le traitement des patients, des perturbations dans les installations industrielles et des litiges éventuels.
Traitement légionellose dans les canalisations, plusieurs solutions sont disponibles :
- Traitement thermique : L’une des méthodes les plus efficaces dans le traitement légionellose consiste à maintenir les températures de l’eau dans les canalisations à des niveaux élevés (supérieurs à 60°C) pour tuer les bactéries. Cependant, cette méthode est ponctuelle, énergivore et peut causer des problèmes de sécurité.
- Désinfection chimique : L’utilisation de produits chimiques désinfectants, tels que le chlore, le dioxyde de chlore ou le peroxyde d’hydrogène, peut aider à éliminer ponctuellement Legionella des canalisations. Il est important de suivre des protocoles stricts pour garantir une désinfection efficace sans causer de problèmes de santé ou de corrosion.
- Filtration : L’installation de filtres à mailles fines peut aider à éliminer les particules de Legionella des systèmes de canalisations.
- Maintenance préventive : La prévention est la clé. Une maintenance régulière des systèmes de canalisations, y compris le nettoyage et la désinfection, peut aider à prévenir la prolifération de Legionella.
- Surveillance continue : La surveillance constante de la qualité de l’eau et la mise en place de systèmes de détection précoce de Legionella peuvent contribuer à une réponse rapide en cas d’infection.
En quoi le procédé ®ACQUAPROCESS est-il la solution pour le traitement légionellose dans les canalisations ?
Le procédé d’Induction à Ultra Basse Fréquence (U.L.F.) ®ACQUAPROCESS est un procédé unique qui présente un potentiel indéniable dans le traitement légionellose dans les canalisations. Cette méthode utilise des champs électromagnétiques à ultra basse fréquence pour perturber la croissance et la survie des bactéries, y compris Legionella pneumophila, dans les systèmes de canalisations.
Voici comment le procédé U.L.F. peut contribuer à l’élimination de la légionellose dans les canalisations :
- Inhibition de la croissance bactérienne : Les champs électromagnétiques à ultra basse fréquence peuvent interférer avec la capacité des bactéries à se reproduire. Cela limite la multiplication de Legionella dans les canalisations, réduisant ainsi la concentration de la bactérie et le risque d’exposition humaine.
- Prévention de la formation de biofilms : Legionella a tendance à se développer dans des biofilms bactériens qui se forment à l’intérieur des canalisations. Le procédé U.L.F. perturbe la formation de ces biofilms en empêchant les bactéries de s’attacher aux parois des tuyaux, réduisant ainsi leur capacité à se développer et à se multiplier.
- Sécurité et respect de l’environnement : Contrairement à la plupart des traitements chimiques, l’Induction à Ultra Basse Fréquence ne nécessite pas l’utilisation de produits chimiques agressifs. Cela le rend plus respectueux de l’environnement et moins préjudiciable à la santé humaine. De plus, il ne génère pas de sous-produits nocifs.
- Coût énergétique réduit : Le procédé U.L.F. ®ACQUAPROCESS consomme très peu d’énergie, ce qui en fait une option économique à long terme pour la prévention de la légionellose dans les canalisations. Il ne nécessite pas de chauffage excessif de l’eau, comme c’est le cas avec d’autres méthodes thermiques, ce qui réduit considérablement la consommation d’énergie globale du système.
- Facilité d’installation et de maintenance : Le système ®ACQUAPROCESS est facile à installer et à entretenir. Il peut être adapté à diverses tailles et configurations de canalisations.
Notre procédé unique ®ACQUAPROCESS présente de nombreux avantages pour combattre la légionellose dans les canalisations, notamment en inhibant la croissance bactérienne, en prévenant la formation de biofilms, en étant respectueux de l’environnement et en offrant une option économe en énergie. Notre procédé est également une solution idéale pour le traitement de l’eau.
Voir l’article issu du Ministère de la Santé et de la Prévention :
Prévention de la légionellose : les obligations par type d’installation et d’établissement.